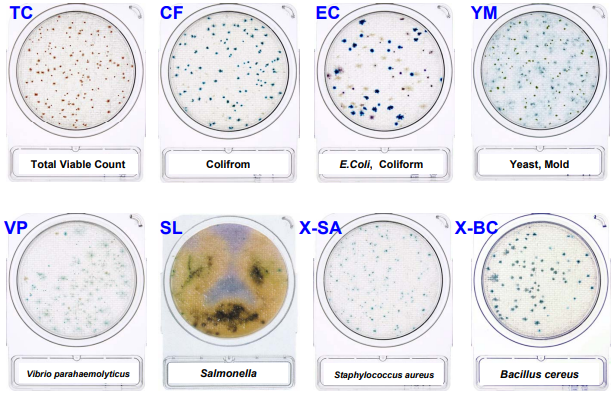

INTRODUCTION
Special Consumables Support
We are providing rapid pathogen testing products and food safety products to our customers.
Below are some of the product brands supplying by us:
- Shimadzu Diagnostics Corporation, Japan – Compact Dry TC, EC, YMR, etc
- Romer Labs – Food Pathogens testing consumables, Food Allergens test kit and etc
- Interscience – Bag Filter and etc
- Kikkoman Biochemifa Company – Rapid Hygiene Monitoring System: LuciPac, Lumitester and etc
- Precision Laboratories – pH test strips, sanitizer test strips, Water quality test strips and etc
- Westlab – Buffer pH solution, Storage Solution and etc.
MICROBIOLOGICAL & CHEMICALS CONSUMABLES & APPLICATION
Get a FREE Quotation and Consultation
We are here to assist. Contact us by WhatsApp